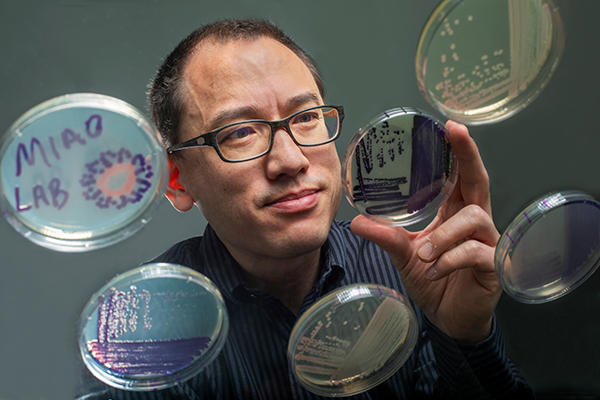
Ed Miao

A Bold New Effort Aims to Harness the Mechanisms of Resilience
Duke University in 2019 initiated a university-wide effort to elevate and sustain excellence in the sciences with new funding for research, recruitment of nationally recognized scholars, and retainment of highly regarded scientific leaders at Duke. Launched with a $100 million investment from The Duke Endowment — divided equally between the university and the School of Medicine — Duke Science and Technology (DST) positions Duke to maximize the potential of revolutionary advances in fields such as genomics, data science, and artificial intelligence.
The effort focuses on three broad thematic pillars: Resilience: Fortifying the Body and Brain, which seeks to harness the body’s intrinsic mechanisms to fight disease; Computing, involving fields such as artificial intelligence and machine learning; and Materials Science, which seeks to engineer new materials to solve challenges in disparate fields.
School of Medicine researchers are leading in efforts to advance the Body and Brain Resilience pillar, focusing on four broad areas where Duke has significant strengths: brain, cancer, immunology, and viruses. Seven DST Scholars have been recruited as faculty in the School of Medicine.
Visit Duke Science and Technology